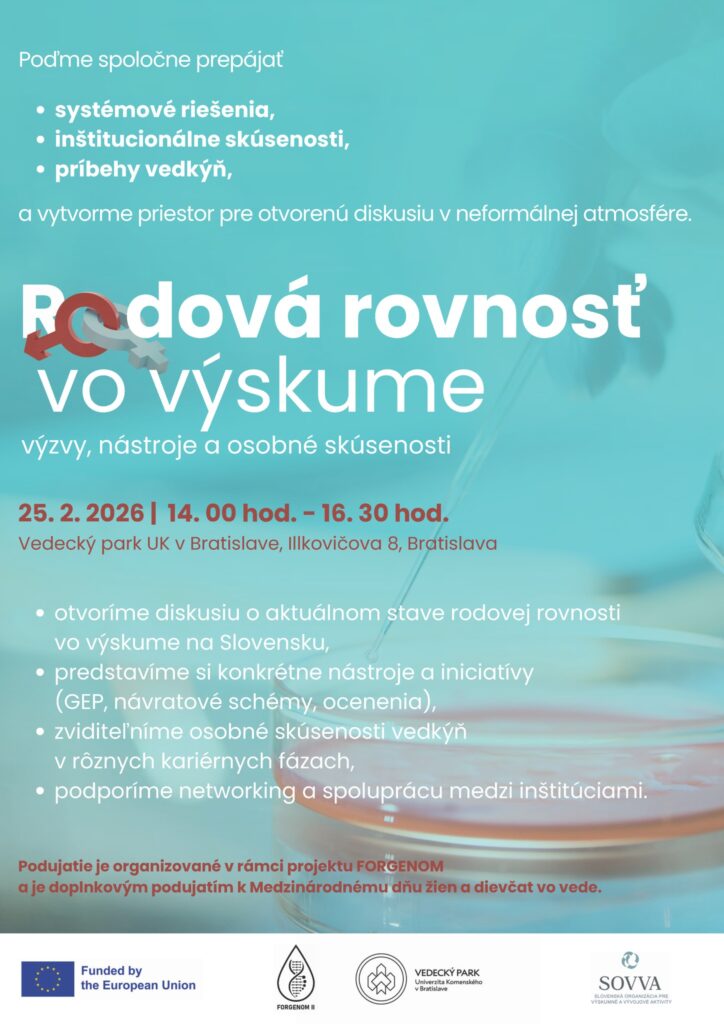
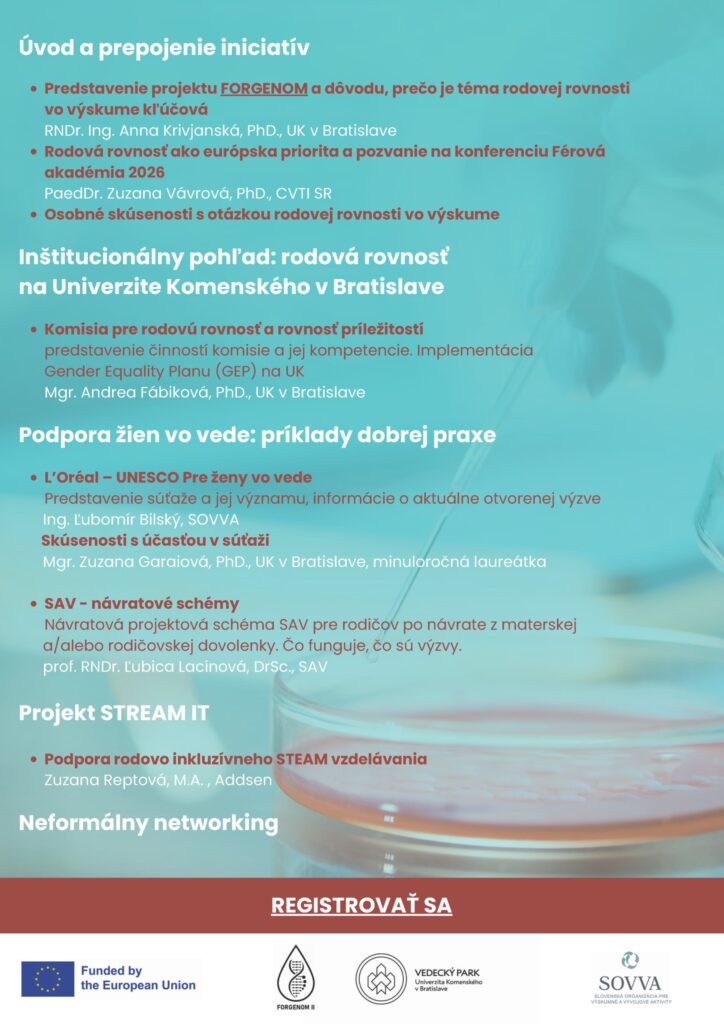

Začiatok: 25. 02. 2026 14:00
Koniec: 25. 02. 2026 16:30
Typ podujatia: Diskusia
Organizátor: Vedecký park Univerzity Komenského v Bratislave
Miesto konania: Vedecký park UK, Ilkovičova 8, Bratislava
Štát: Slovensko
Ako partner podujatia organizovaného Vedeckým parkom Univerzity Komenského v Bratislave v rámci projektu FORGENOM vás SOVVA pozýva na odbornú diskusiu Rodová rovnosť vo výskume – výzvy, nástroje a osobné skúsenosti.
Diskusia otvorí tému aktuálneho stavu rodovej rovnosti vo výskume na Slovensku a predstaví konkrétne nástroje, iniciatívy a systémové riešenia, ktoré podporujú ženy vo vede. Súčasťou budú aj osobné skúsenosti vedkýň v rôznych kariérnych fázach.
Témy podujatia:
▪ implementácia Gender Equality Plan (GEP) v rámci programu Horizon Europe
▪ činnosť univerzitnej Komisie pre rodovú rovnosť a rovnosť príležitostí
▪ príklady dobrej praxe (návratové schémy Slovenská akadémia vied, súťaž L’Oréal – UNESCO Pre ženy vo vede)
▪ projekt STREAM IT a rodovo inkluzívne vzdelávanie
Kedy: 25. 2. 2026
🕑 14:00 – 16:30
Kde: Ilkovičova 8, Bratislava
Podujatie ponúkne priestor aj na networking a spoluprácu medzi inštitúciami.
Účasť je bezplatná, potrebná je registrácia cez elektronický formulár:
Zdroj: SOVVA, zverejnené: 19.2.2026; autor: rup



